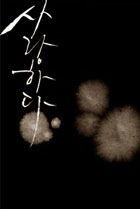
주니오니

욕심을 버리려고 사는 것 같습니다.
욕심을 버리려면 채워지거나 포기하거나 초월해야 합니다.
돈을 많이 벌고자 노력하거나
멋진 이성을 만나고 싶거나
이름을 널리 알리고 싶거나
은둔형 외톨이가 되거나
수도를 하거나
결국엔 어떤 식으로든 욕심을 버리려는 것인데
채워지지 않는 갈증처럼
끝없는 욕심이 사람을 살게 하는 것이죠.
손에 넣어도 허전한,
혼자 있으면, 때때로 같이 있어도 외로운,
수양에 수양을 거듭하여도 끝이 없는 이유는,
욕심을 버리지 못했기 때문입니다.
역설적으로 그것이
사람을 살아있게 합니다.
그리고 결국 그 어떤 수단, 방법으로도
채워질 수도 포기할 수도 초월할 수도 없음을 깨달았을 때 극단을 향하게 되어
살아있음에서 벗어나거나
비로소 살아있음 이상이 됩니다.
바닷물 같은 욕심을 마시며
마지막을 향해 느리지만 꾸준히 걷는 일
그게 인생인가 봅니다.
댓글 11개
베스트 댓글
게시글 목록
| 번호 | 제목 |
|---|---|
| 1717629 | |
| 1717626 | |
| 1717625 | |
| 1717621 | |
| 1717619 | |
| 1717611 | |
| 1717610 | |
| 1717609 | |
| 1717607 | |
| 1717601 | |
| 1717598 | |
| 1717591 | |
| 1717590 | |
| 1717583 | |
| 1717575 | |
| 1717572 | |
| 1717568 | |
| 1717566 | |
| 1717549 | |
| 1717545 | |
| 1717533 | |
| 1717512 | |
| 1717511 | |
| 1717508 | |
| 1717495 | |
| 1717479 | |
| 1717473 | |
| 1717470 | |
| 1717463 | |
| 1717452 |

댓글 작성
댓글을 작성하시려면 로그인이 필요합니다.
로그인하기